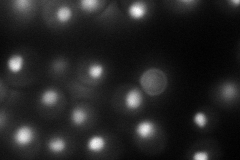
YOR123C
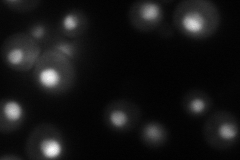
YOR123C

View description
Component of the Paf1 complex, which associates with RNA polymerase II and is involved in histone methylation; plays a role in regulating Ty1 transposition
Localization:
Intensity:
Fold change:
Significance:
-
C’ GFP library in SD

below threshold14.91 -
N' NOP1pr-GFP in SD
nucleus100.15 -
N' TEF2pr-mCherry in SD
nucleus90.2449 -
N' NATIVEpr-GFP in SD

missing0 -
N' TEF2pr-VC and Cyto-VN in SD

#N/A0 -
C’ GFP library in SD+DTT

cytosol17.011.14No -
C’ GFP library in SD+H2O2

cytosol17.361.16No -
C’ GFP library in Starvation Media

cytosol18.411.23No -
C’ GFP library on the background of Pup2-DaMP

below threshold -
C’ GFP library on the background of CCT mutant

below threshold15.68181.05105No
